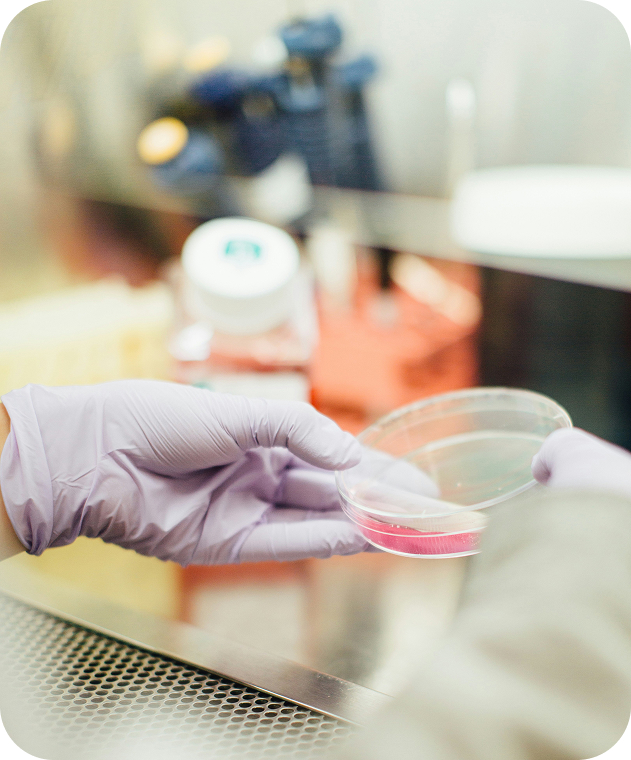
Preci Laboratories

About Preci
Preci was created to explore the diversity of the primary human cell models using emergent technologies and to simplify the routine of researchers working in target discovery, biomarker research, and preclinical studies. To follow this mission we have created three ecosystems of products, namely, DMPK human-derived products, human-derived ECMs and primary isolated human cell products.
Improving the reliability and availability of translational models brings us closer to uncovering new therapies, transforming the landscape of drug discovery worldwide.

Our valuesLean more
Ethics first
We maintain the highest ethical standards while collecting human tissues. No shortcuts in adherence to the international regulations can be allowed.
Quality over quantity
Lowest ischemia time should be secured and careful sample stabilisation is performed in order to generate high-quality products.
Every specimen matters
Every sample needs to be treated and processed on the individual basis to secure its integrity and generate the high-quality products from that.
Innovating Human ResearchFrom advanced cell models to 3D culture systems — we make translational science simpler, more reproducible, and cost-effective.View All Products
Ethical PrinciplesWe uphold the highest ethical standards in every aspect of our research, ensuring respect for human dignity, transparency, and trust in science.

At Preci, we believe that advancing science is only meaningful when built on the foundation of integrity and respect. Our commitment to the highest ethical standards guides every step, ensuring that our work not only innovates but honors the trust placed in us by our partners and society.
Preci as a supplierReliable, high-quality cell products when you need themView All Products
From Uncertainty to Reliability with Preci
Before Preci
- Large bath procurement is needed to ensure the constant product availability
- After the stock exhaustion, no further predicablity can be developed
- Immediate investment needs to be made to procure the whole primary
- Experimental validation of the new batch should be perfomend
With Preci
- Batches can be reserved and stocked for up to 3 years at our stock
- We ensure that the next batch will match your project expectation
- No immediate purchase is required. Purchase your stocked batches, when you need that
- Validation of matching your expectation is performed by Preci. We will make product which will surely match your expectations
Immediate purchase requirements for cellular products can strain research budgets and introduce unnecessary risks. When researchers are forced to buy in bulk or stockpile products without precise knowledge of future needs, they often end up overspending on materials that may not be used within their optimal timeframe. This not only leads to wasted funds but also increases the likelihood of degraded quality over time, potentially compromising experimental outcomes. Furthermore, buying large quantities up front ties up valuable budget resources that could be better allocated elsewhere, limiting flexibility for future project adjustments or new opportunities.
Preci improves this critical aspect of research by offering a flexible, on-demand supply model that eliminates the need for bulk purchasing and stockpiling. By providing fresh, high-quality cellular products precisely when they are needed, we help researchers avoid the risks of degraded quality, overspending, and wasted resources. Our tailored approach ensures that you can adapt to the evolving needs of your project, optimize your budget, and maintain the consistency and reliability of your experiments without being locked into unnecessary or premature purchases. Preci empowers your research to be both cost-effective and scientifically sound.